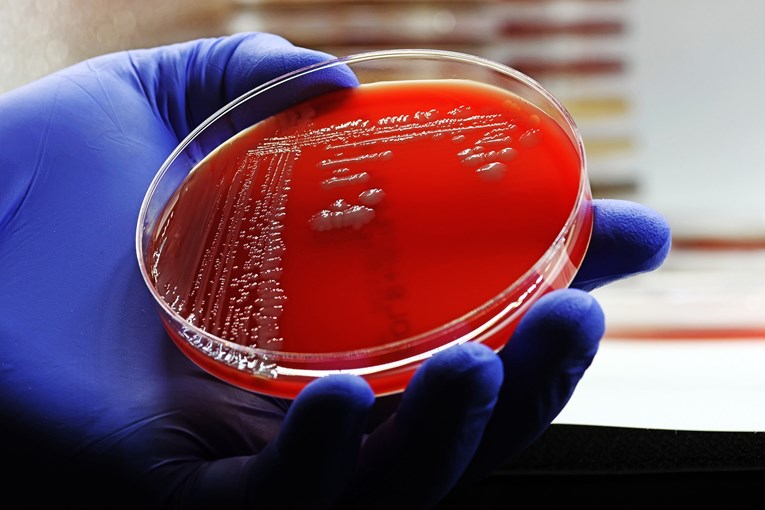
Tiha pandemija prijeti svijetu: Cijena otpornosti na antibiotike bit će golema

Tiha pandemija prijeti svijetu: Cijena otpornosti na antibiotike bit će golema
SVIJET se suočava s tihom pandemijom koja bi do 2050. godine mogla odnositi milijune života i globalno gospodarstvo koštati gotovo dva bilijuna dolara godišnje. Riječ je o superbakterijama, mikroorganizmima otpornima na antibiotike, čije širenje prijeti katastrofalnim zdravstvenim i ekonomskim posljedicama, otkriva najnovije istraživanje financirano od strane britanske vlade, koje ekskluzivno donosi Guardian.
Ako se ne poduzmu odlučni koraci, rastuća otpornost na antimikrobne lijekove (AMR) mogla bi u sljedećih četvrt stoljeća smanjiti globalni BDP za čak 1,7 bilijuna dolara godišnje. Istraživanje analitičkog centra Center for Global Development upozorava da bi upravo najrazvijenija gospodarstva, poput SAD-a, Ujedinjenog Kraljevstva i Europske unije, mogla pretrpjeti najteže udarce. Ova spoznaja baca novo svjetlo na nedavne odluke o drastičnom smanjenju sredstava za međunarodnu pomoć, koje se sada čine potpuno kontraproduktivnima.
Ironično, upravo su vlade nekih od najugroženijih zemalja nedavno najavile rezove. Britanska vlada ukinula je financiranje za Flemingov fond, ključan za borbu protiv AMR-a u siromašnijim zemljama. Istovremeno, administracija u SAD-u potvrdila je smanjenje proračuna za inozemnu pomoć za 9 milijardi dolara, a slične su poteze povukle i Francuska te Njemačka.
Cijena nečinjenja je previsoka
Anthony McDonnell, vodeći autor studije iz Centra za globalni razvoj, ističe kako bi ovakvi potezi mogli ubrzati ostvarenje najcrnjih prognoza. "Naša su se predviđanja temeljila na povijesnim trendovima rasta otpornosti. Međutim, iznenadni i oštri rezovi u razvojnoj pomoći mogli bi gurnuti stope otpornosti prema najpesimističnijem scenariju", upozorava McDonnell.
"Čak ni zemlje koje uspješno kontroliraju otpornost na antibiotike ne smiju se opustiti. Ako se programi za borbu protiv AMR-a ne zaštite od rezova, otpornost će se širiti svijetom brzinom koju vidimo u najpogođenijim državama. To bi značilo milijune novih smrtnih slučajeva, uključujući i u zemljama skupine G7. Ulaganje u liječenje bakterijskih infekcija danas spašava živote i donosi milijarde dugoročne ekonomske koristi", zaključuje.
Alarmantne brojke za najveća gospodarstva
Prema najgorem scenariju, istraživanje predviđa da bi do 2050. godine godišnji gubici BDP-a u Kini mogli dosegnuti 722 milijarde dolara, u SAD-u 295,7 milijardi, u EU 187 milijardi, u Japanu 65,7 milijardi, a u Ujedinjenom Kraljevstvu 58,6 milijardi dolara.
Institut za zdravstvenu metriku i evaluaciju (IHME) procjenjuje da će se broj smrti uzrokovanih otpornošću na antibiotike do 2050. povećati za 60 posto. Samo u SAD-u predviđa se 1,34 milijuna smrtnih slučajeva godišnje, a u Velikoj Britaniji 184.000. Superbakterije uzrokuju češće hospitalizacije, dulje i intenzivnije liječenje te zahtijevaju skuplje lijekove druge linije, zbog čega je liječenje otpornih infekcija otprilike dvostruko skuplje.
Studija procjenjuje da bi globalni zdravstveni troškovi liječenja AMR-a mogli porasti za gotovo 176 milijardi dolara godišnje. U Velikoj Britaniji taj bi skok iznosio s 900 milijuna na 3,7 milijardi dolara, a u SAD-u s 15,5 milijardi na gotovo 57 milijardi dolara. Uz to, radna snaga u UK-u, EU i SAD-u smanjila bi se za 0,8, 0,6 odnosno 0,4 posto.
Ulaganje se višestruko isplati
S druge strane, ako zemlje pojačaju borbu protiv superbakterija – osiguravanjem pristupa novim antibioticima i kvalitetnijim liječenjem – ekonomske koristi bile bi goleme. Gospodarstvo SAD-a do 2050. raslo bi za dodatnih 156,2 milijarde dolara godišnje, a britansko za 12 milijardi dolara.
Dr. Mohsen Naghavi, profesor na IHME-u, poručuje: "Prijetnja raste i bez hitne akcije svih uključenih strana, lijekovi koje danas imamo mogli bi postati beskorisni, pretvarajući i najobičniju infekciju u smrtonosnu bolest." To, kako dodaje, zahtijeva promjenu politika, razvoj novih lijekova i podizanje svijesti da antibiotici ne djeluju protiv virusa.
Glasnogovornik britanske vlade izjavio je kako njihov desetogodišnji zdravstveni plan prepoznaje AMR kao veliku prijetnju. "Postigli smo važan napredak - smanjili smo upotrebu antibiotika u proizvodnji mesa i uveli pionirski model pretplate kako bismo potaknuli razvoj novih lijekova. Nastavljamo blisku suradnju s međunarodnim partnerima u borbi protiv širenja AMR-a", stoji u priopćenju.

bi Vas mogao zanimati
Izdvojeno
Pročitajte još
bi Vas mogao zanimati